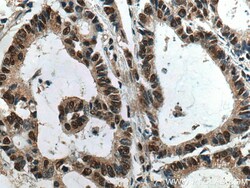
HNRNPK Mouse Monoclonal Antibody, Proteintech Unconjugated; 150 &mu;L:Antibodies,

missing translation for 'onlineSavingsMsg'
Learn More
Learn More
HNRNPK Mouse Monoclonal Antibody, Proteintech
Mouse Monoclonal Antibody
Brand: Proteintech 67708-1-IG-150UL
This item is not returnable.
View return policy
Description
The HNRNPK antibody from Proteintech is a mouse monoclonal antibody generated with recombinant protein of human HNRNPK. This antibody recognizes human, mouse, rat antigen. The HNRNPK antibody has been validated for the following applications: WB, IHC, ELISA analysis.Specifikationer
| HNRNPK | |
| Monoclonal | |
| 500 μg/mL | |
| CSBP; FLJ41122; HNRPK; TUNP | |
| Recombinant Protein | |
| 150 μL | |
| Primary | |
| Human, Mouse, Rat | |
| 60 kDa | |
| Liquid |
| Western Blot, Immunohistochemistry, ELISA | |
| 1A10C8 | |
| Unconjugated | |
| Mouse | |
| Thiophilic affinity chromatograph | |
| RUO | |
| 3190 | |
| Store at -20°C. Stable for one year after shipment. | |
| Monoclonal Antibody | |
| IgM |
Korrigering av produktinnehåll
Din input är viktig för oss. Fyll i det här formuläret för att ge feedback relaterad till innehållet på denna produkt.
Produkttitel
Hittar du en möjlighet till förbättring?Dela en innehållskorrigering